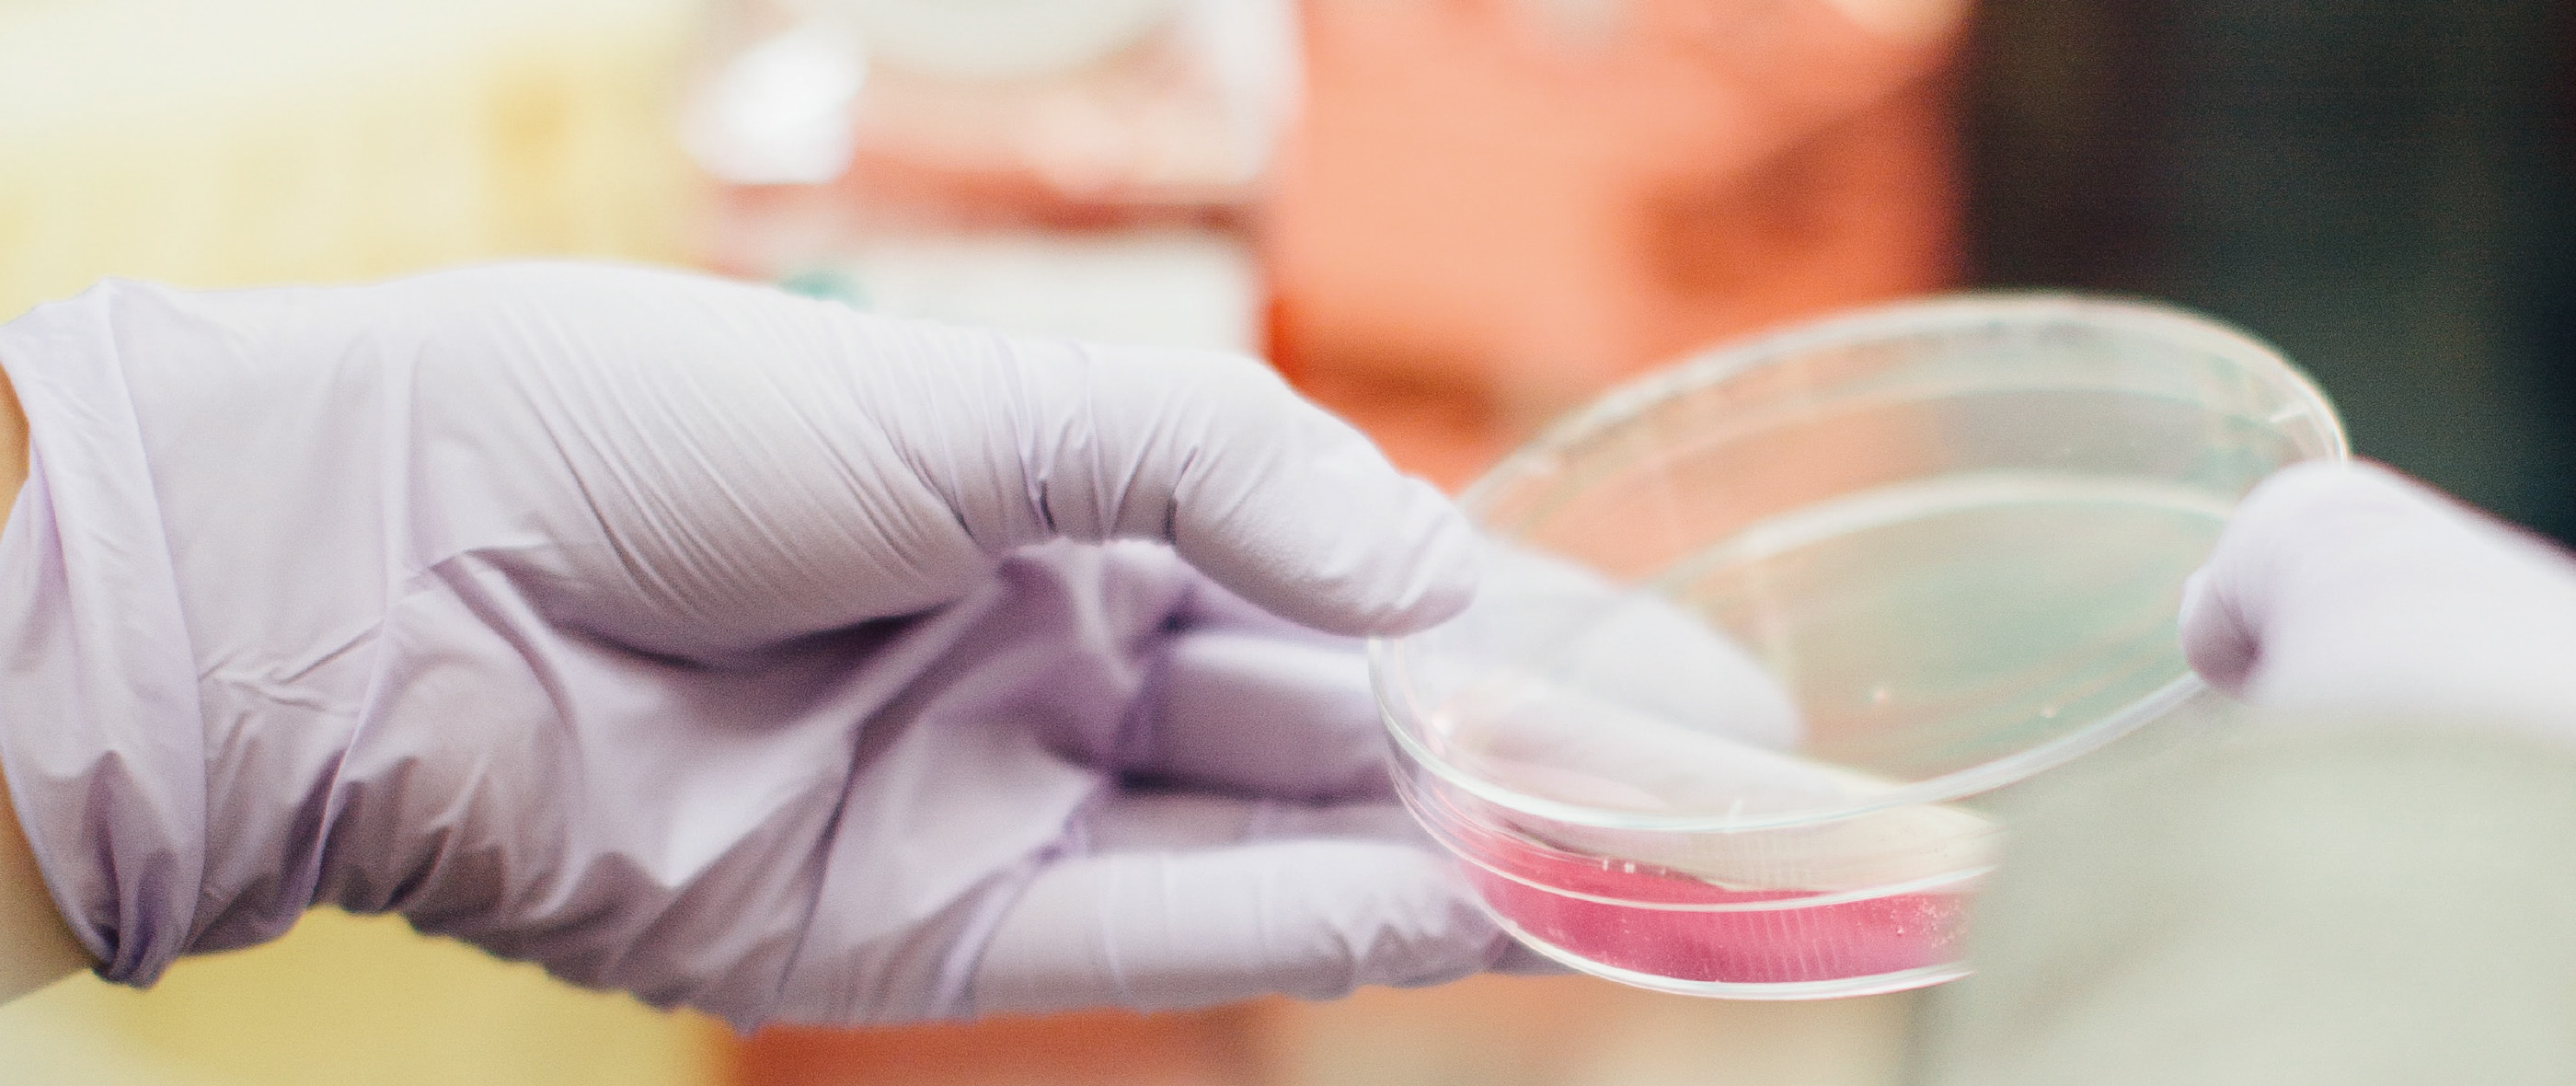
Ultraviolet sterilization，UVC，Portable，European product design award，

At the moment when 2019-nCoV is ravaging the world. UVC LED Wand Sanitizer is a portable ultraviolet disinfection instrument that can emit 265nm ultraviolet rays. UV-C prevent the reproduction of microorganisms (bacteria, viruses and other pathogen cells) by destroying DNA and RNA. The simple and elegant beauty is suitable for home and travel use, ergonomic design, good use experience and efficiency, and stands out from similar products that have been launched.
The design language is inspired by Scandinavian design features. The combination of simplicity, minimalism, functionality and easy user interaction builds the foundation of the product.
Brand: Senerport
Listing Date: Early 2020
Rendering: Keyshot


Ergonomic design, good use experience and efficiency. The 9-degree angle tilt design of the luminous surface allows the wrist to maintain a natural and comfortable physiological curvature when used. Because ultraviolet light directly irradiates the human body is harmful, the safety angle formed by the 9-degree angle tilt design protects the hands from being directly irradiated by UVC.
The built-in intelligent sensor will flash orange when the angle deflection is greater than 90 degrees.
Multiple safety design and child lock design to prevent children from accidentally opening and being accidentally injured by ultraviolet rays;

The copyright of this work belongs to Bill. No use is allowed without explicit permission from owner.

New user?Create an account
Log In Reset your password.
Account existed?Log In
Read and agree to the User Agreement Terms of Use.

Please enter your email to reset your password
Kissing UV disinfection takes more than ten minutes to be useful. Oh, is it ten minutes with your hands?
Very good✨✨✨✨✨✨✨✨✨✨✨
Great design!
Very good
Nice design
This is very convenient and practical.
Good
This shape
This shape is very tall, nice.
Crooked Ruigold
The styling is very practical, suitable for easy access at home, and the handheld styling is not abrupt, great
very good design, can the TOP list be warned?
At present, the habit of using sterilizers in China has not been cultivated yet ~ the future will definitely be hot.
Quality loves! Simple shape and elegant aesthetic feeling suitable for home and travel, super portable